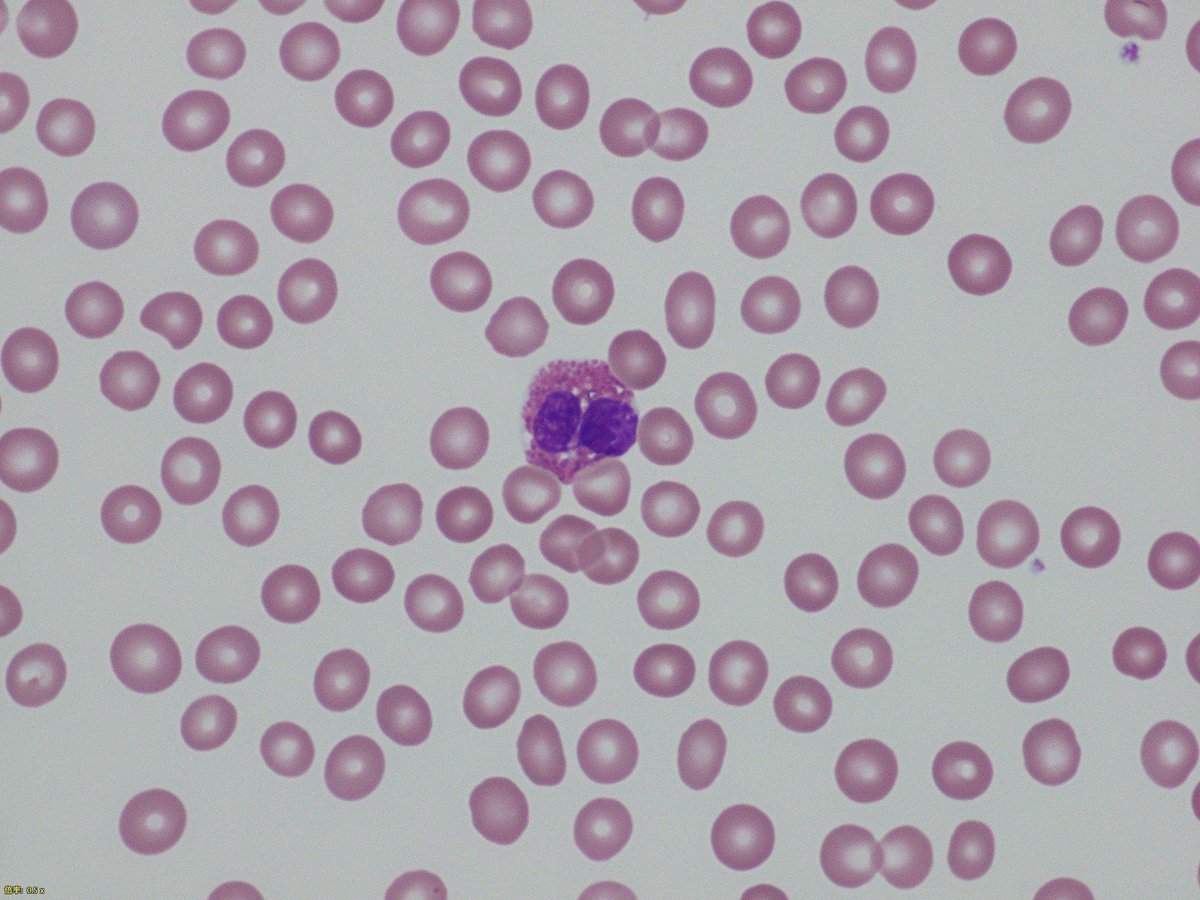

好酸球
- 大きさ : 中、12-15 µm
- N/C比= 中、0.4
- 細胞質
- 広さ : 広い
- 好塩基性 : 無
- 顆粒の数 : 多数
- 顆粒の色 : オレンジ色=好酸球
- 膜 : 異常なし
- 核
- 位置 : 中央
- クロマチン : 粗剛
- 核小体 : 無
- 膜 : 異常なし
- 基準値 : 0.5 x 109/L未満
- 細胞学的・臨床病理学的所見
財布のように折れ曲がり、クロマチンが濃縮した核の中型の円形細胞。ビーズがびっしりと詰まったような非常に大きい好酸性顆粒が細胞質にみられる。
大きなオレンジ色の顆粒(好酸球顆粒)は好酸球の特徴である。この好酸球顆粒は寄生虫(回虫、ミクロフィラリア、住血吸虫)と哺乳類の細胞にとっては有害であることが知られている。
寄生虫感染とアレルギーによる好酸球増加
突発性好酸球増加:異常な好酸球(顆粒の減少した好酸球、顆粒の形態異常の好酸球)が見られる。最近ではFIP1L2-PDGFRa融合遺伝子による分子異常がみられる。
血液疾患に関連した好酸球増加:T細胞リンパ腫、ホジキン病、CML(慢性骨髄性白血病)